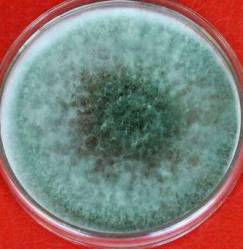
毛霉属毛霉的菌丝体发达,菌落质地疏松,呈棉絮状,由许多分枝的菌丝

毛霉匍匐菌丝

要我做腐乳还要我不感染毛霉这事挺难
图片尺寸640x424
毛霉目
图片尺寸1080x2287
霉菌是丝状真菌的俗称,意即"发霉的真菌"
图片尺寸640x640
这个发霉的草莓还有救吗
图片尺寸1080x810
发霉食物去掉坏的部分还能不能吃
图片尺寸600x333
匍匐菌丝
图片尺寸900x681
菌丝间细小的颗粒是散落的孢子,那是毛豆腐成熟的标志.
图片尺寸600x450
种丝状真菌,分布广泛,常见于土壤,水果,豆腐等上,具有发达的白色菌丝
图片尺寸668x927
菌丝是这样子的
图片尺寸3000x2000
喜欢
图片尺寸620x547
霉菌菌丝
图片尺寸2667x2000
草莓菌丝01
图片尺寸1080x1439
毛豆腐表面上的绒毛是通过人工发酵产生的,白色的细丝是毛霉菌的菌丝
图片尺寸660x495
一般毛霉目的常会形成匍匐丝,也称匍匐枝,属于菌丝的特化或菌丝的
图片尺寸623x359
毛霉属毛霉的菌丝体发达,菌落质地疏松,呈棉絮状,由许多分枝的菌丝
图片尺寸243x249
大家知道放坏了的水果会"长毛",这些绒毛即是霉菌的菌丝.
图片尺寸640x461
菌丝宽大,无色分枝,几乎无分隔.
图片尺寸1200x1200
一株毛霉菌菌株及在发酵青砖茶上的应用制造技术,发
图片尺寸1000x754
显微镜下的霉菌
图片尺寸761x720
毛霉菌图片
图片尺寸367x300